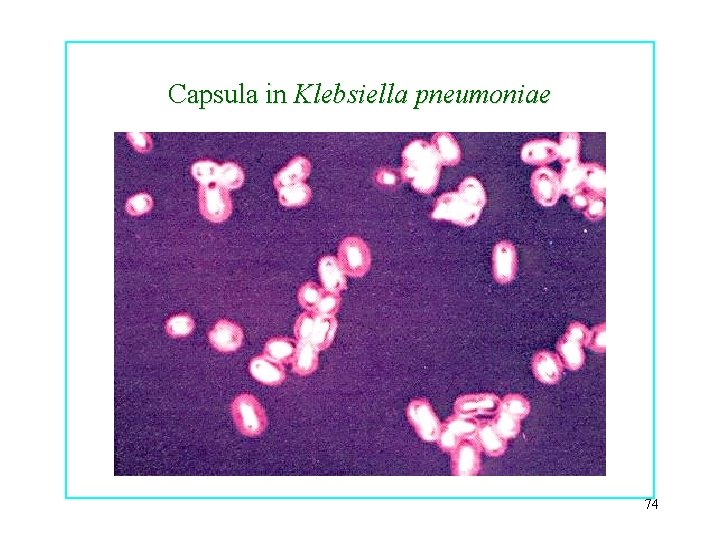
Capsula in Klebsiella pneumoniae 74

Batteri COCCHI SPIROCHETE BASTONCELLI VIBRIONI SPIRILLI 1 FORME

Batteri COCCHI SPIROCHETE BASTONCELLI VIBRIONI SPIRILLI 1 FORME FILAMENTOSE FORME PEDUNCOLATE

DIMENSIONI CELLULARI 250 mm Haemophilus influenzae Epulopiscium fishelsoni 2

Differenti forme batteriche I Diametro da 0. 5 a 1μm Lunghezza da 1 a 4 μm 3

Streptococcus pyogenes 4

Streptococcus pneumoniae 5

Sarcina e tetradi 6

Bacilli e streptobacilli 7

Differenti forme batteriche II Da 1 μm a 100 μm Forme filamentose 8

Vibrio cholerae 9

Spirochete 10

Spirilli 11

Struttura cellula batterica 12

Membrana citoplasmatica 13

Principali funzioni della membrana citoplasmatica 14

Altre funzioni della membrana citoplasmatica • • • Sintesi di peptidoglicano Sintesi dei fosfolipidi Divisione amitotica del nucloide Base dei flagelli Eliminazione delle scorie Formazione di endospore 15

Tre classi di trasporto associate alla membrana 16

Diffusione semplice La diffusione semplice è il passaggio di gas o piccole molecole polari attraverso la membrana da una zona a più alta concentrazione ad una zona a più bassa concentrazione. Il passaggio include molecole N 2, O 2, CO 2, piccole molecole polari come etanolo, acqua ed urea. 17

Diffusione semplice 18

Osmosi L’osmosi è quel fenomeno per cui si assiste al movimento di acqua da una soluzione meno concentrata a una soluzione più concentrata, attraverso una membrana semipermeabile. Per semipermeabile si intende una membrana che permette il passaggio del solvente (per esempio l’acqua) ma non di determinati soluti (per esempio zuccheri e proteine). L’osmosi è supportata dall’energia potenziale di un gradiente di concentrazione e non 19 richiede dispendio di energia metabolica.

Osmosi nei diversi ambienti Isotonico Ipertonico Ipotonico 20

Osmosi in ambiente isotonico 21

Osmosi in ambiente ipertonico 22

Osmosi in ambiente ipotonico 23

Un esempio 24

Passaggio di sostanze attraverso la membrana per mezzo di proteine trasportatrici (carrier proteins) Uniporter Nessuna energia Antiporter Simporter + energia 25

Sistema di trasporto antiporter Antiporters sono proteine che trasportano sostanze attraverso la membrana in una direzione mentre simultaneamente trasportano una seconda sostanza attraverso la membrana in direzione opposta. Ioni 26 sodio e protoni sono co-trasportati attraverso le membrane batteriche.

Sistema di trasporto simporter Simporters sono proteine di trasporto che simultaneamente trasportano due sostanze nella stessa direzione. Solfati, fosfati e protoni sono co-trasportati attraverso le membrane batteriche 27

Forza protonica Il movimento dei protoni attraverso la membrana produce energia. 28

Sistema di trasporto ABC (ATPbinding cassette) 29

Trasporto attraverso la membrana con un sistema ABC Questo tipo di trasporto si trova in vari batteri Gramcoinvolge proteine localizzate nello spazio periplasmico che si legano a substrati specifici. Questo tipo di trasporto include alcuni zuccheri e aminoacidi. 30

Gruppi di traslocazione 31

Trasporto di sostanze attraverso la membrana con un gruppo di traslocazione In questo caso la sostanza è chimicamente alterata durante il trasporto attraverso la membrana. Un gruppo fosfato ad alta energia dal fosfoenolpiruvato è trasferito da vari enzimi al glucosio. Altri zuccheri trasportati sono il mannosio ed il fruttosio 32

Proteine di trasporto della membrana I trasportatori semplici e i sistemi di trasporto tipo ABC trasportano le sostanze senza modificarle chimicamente mentre nella traslocazione di gruppo si ha la modificazione chimica (fosforilazione) della sostanza trasportata. 33

Parete cellulare- peptidoglicano 34

Precursore peptidoglicano Batteri Gram+ Batteri Gram - 35

Peptidoglicano batteri Gram+ 36

Peptidoglicano in batteri Gram- 37

Legame tra le unità peptidiche e glicaniche nella formazione del peptidoglicano Nei batteri Gram-negativi non c’è ponte peptidico e il legame è diretto come invece è presente nei batteri Gram+. Struttura del peptidoglicano, varie catene legate tra 38 loro.

Peptidoglycan synthesis Cytoplasm Cell Membrane Cell wall undecaprenol sugar amino acid 39

Sintesi peptidoglicano 40

Sintesi peptidoglicano 2 41

Sintesi peptidoglicano 3 42

Sintesi peptidoglicano 43

44

Colorazione di Gram 45

Batteri Gram positivi 46

Parete Gram+ • Peptidoglicano • Acidi teicoici: (polimeri di poliolfosfati) legati covalentemente al peptidoglicano • Acidi lipoteicoici: ancorati alla membrana citoplasmatica (fattori di virulenza favoriscono l’adesione) • Proteine (proteina M streptococchi, proteina A stafilococchi) 47

Acido teicoico L’acido teicoico è un polimero che deriva dalla polimerizzazione dell’unità di ripetizione del ribitolo 48

Glicoproteina M 49

Sintesi peptidoglicano batteri Gram+ 50

Effetto dei frammenti del peptidoglicano e degli acidi teicoici durante l’infezione dei batteri Gram + 51

Meccanismo d’azione peptidoglicano 52

Eccessiva produzione di citochine durante l’infezione sistemica da Gram + 53

Batteri Gram negativi 54

Parete Gram • Strato sottile di peptidoglicano 5 -10% • Membrana esterna • Spazio periplasmico (enzimi idrolitici: proteasi, lipasi. fattori litici di virulenza: collagenasi, beta-lattamasi. Sistema di trasporto degli zuccheri) 55

Sintesi peptidoglicano batteri Gram- 56

Parete cellulare Gram-negativi 57

Membrana esterna (gram-) • Barriera impermeabile a grosse molecole (lisozima, molecole idrofobiche) • Protezione dalle condizioni ambientali avverse (sistema digestivo dell’ospite) • Strato interno: fosfolipidi • Strato esterno: molecola anfipatica (terminazioni idrofobiche ed idrofiliche) lipopolisaccaride (LPS) • Proteine che attraversano il doppio strato lipidico: porine (passaggio di metaboliti e piccoli antibiotici idrofili) 58

Membrana esterna (GRAM-) • Recettori molecolari • Legata al peptidoglicano covalentemente: lipoproteina di brown • Tenuta insieme da: legami tra Mg++, Ca++ e fosfati ed interazioni idrofobiche 59

LPS 60

Struttura del lipopolisaccaride I componenti chimici del lipide A del polisaccaride variano a seconda della specie , ma la sequenza dei componenti più importanti (lipide A-ketodeossiottonato- core-O-specifico) è generalmente uniforme. Il polisaccaride O specifico varia da una specie all’altra. Il lipide A è quella porzione del LPS che può essere tossica per gli animali e costituisce il complesso endotossinico. 61

62

Effetto tossico LPS 63


Meccanismo d’azione LPS 65

Eccessiva produzione di citochine nell’infezioni sistemiche da batteri Gram- 66

Shock tossico 67

Caratteristiche dei rivestimenti dei batteri Gram-positivi e Gram-negativi Caratteristiche Gram-positivi Gram-negativi Membrana esterna - + Parete Più spessa Più sottile LPS - + Endotossina - + Acido teicoico Spesso presente Assente Sporulazione Alcuni ceppi Nessuno Capsula Talvolta presente Lisozima Sensibili Resistenti Attività antibatterica della penicillina Più sensibili Più resistenti Produzione di esotossina Alcuni ceppi 68

Batteri acido resistenti 69

Batteri acido resistenti Micobatteri, Nocardia e Corinebateri) • Il peptidoglicano ricco di – Acidi micolici polisaccaridi • Membrana esterna – complesso di lipidi e cere 70

Batteri acido resistenti 71

Strutture esterne § § § Capsula : strato ben organizzato aderente alla parete batterica di natura polisaccaridica o proteica Strato mucoso: strato poco aderente e poco uniforme, facilmente rimovibile di natura polisaccaridica Glicocalice: rete di polisaccaridi può circondare la capsula e lo strato mucoso, favorisce l’attecchimento del batterio 72

Capsula § Protegge la cellula dalla fagocitosi (fattore di virulenza). § Barriera per molecole idrofobiche tossiche (detergenti) § Favorisce l’adesione ad altri batteri alle superfici dei tessuti dell’ospite § Spesso non è presente nelle colture in vitro 73
Capsula in Klebsiella pneumoniae 74

Capsula 75

Fagocitosi 76

Fagocitosi per mezzo dell’opsonizzazione 77

Blocco della fagocitosi 78

Biofilm 79

Biofilm
- Slides: 80